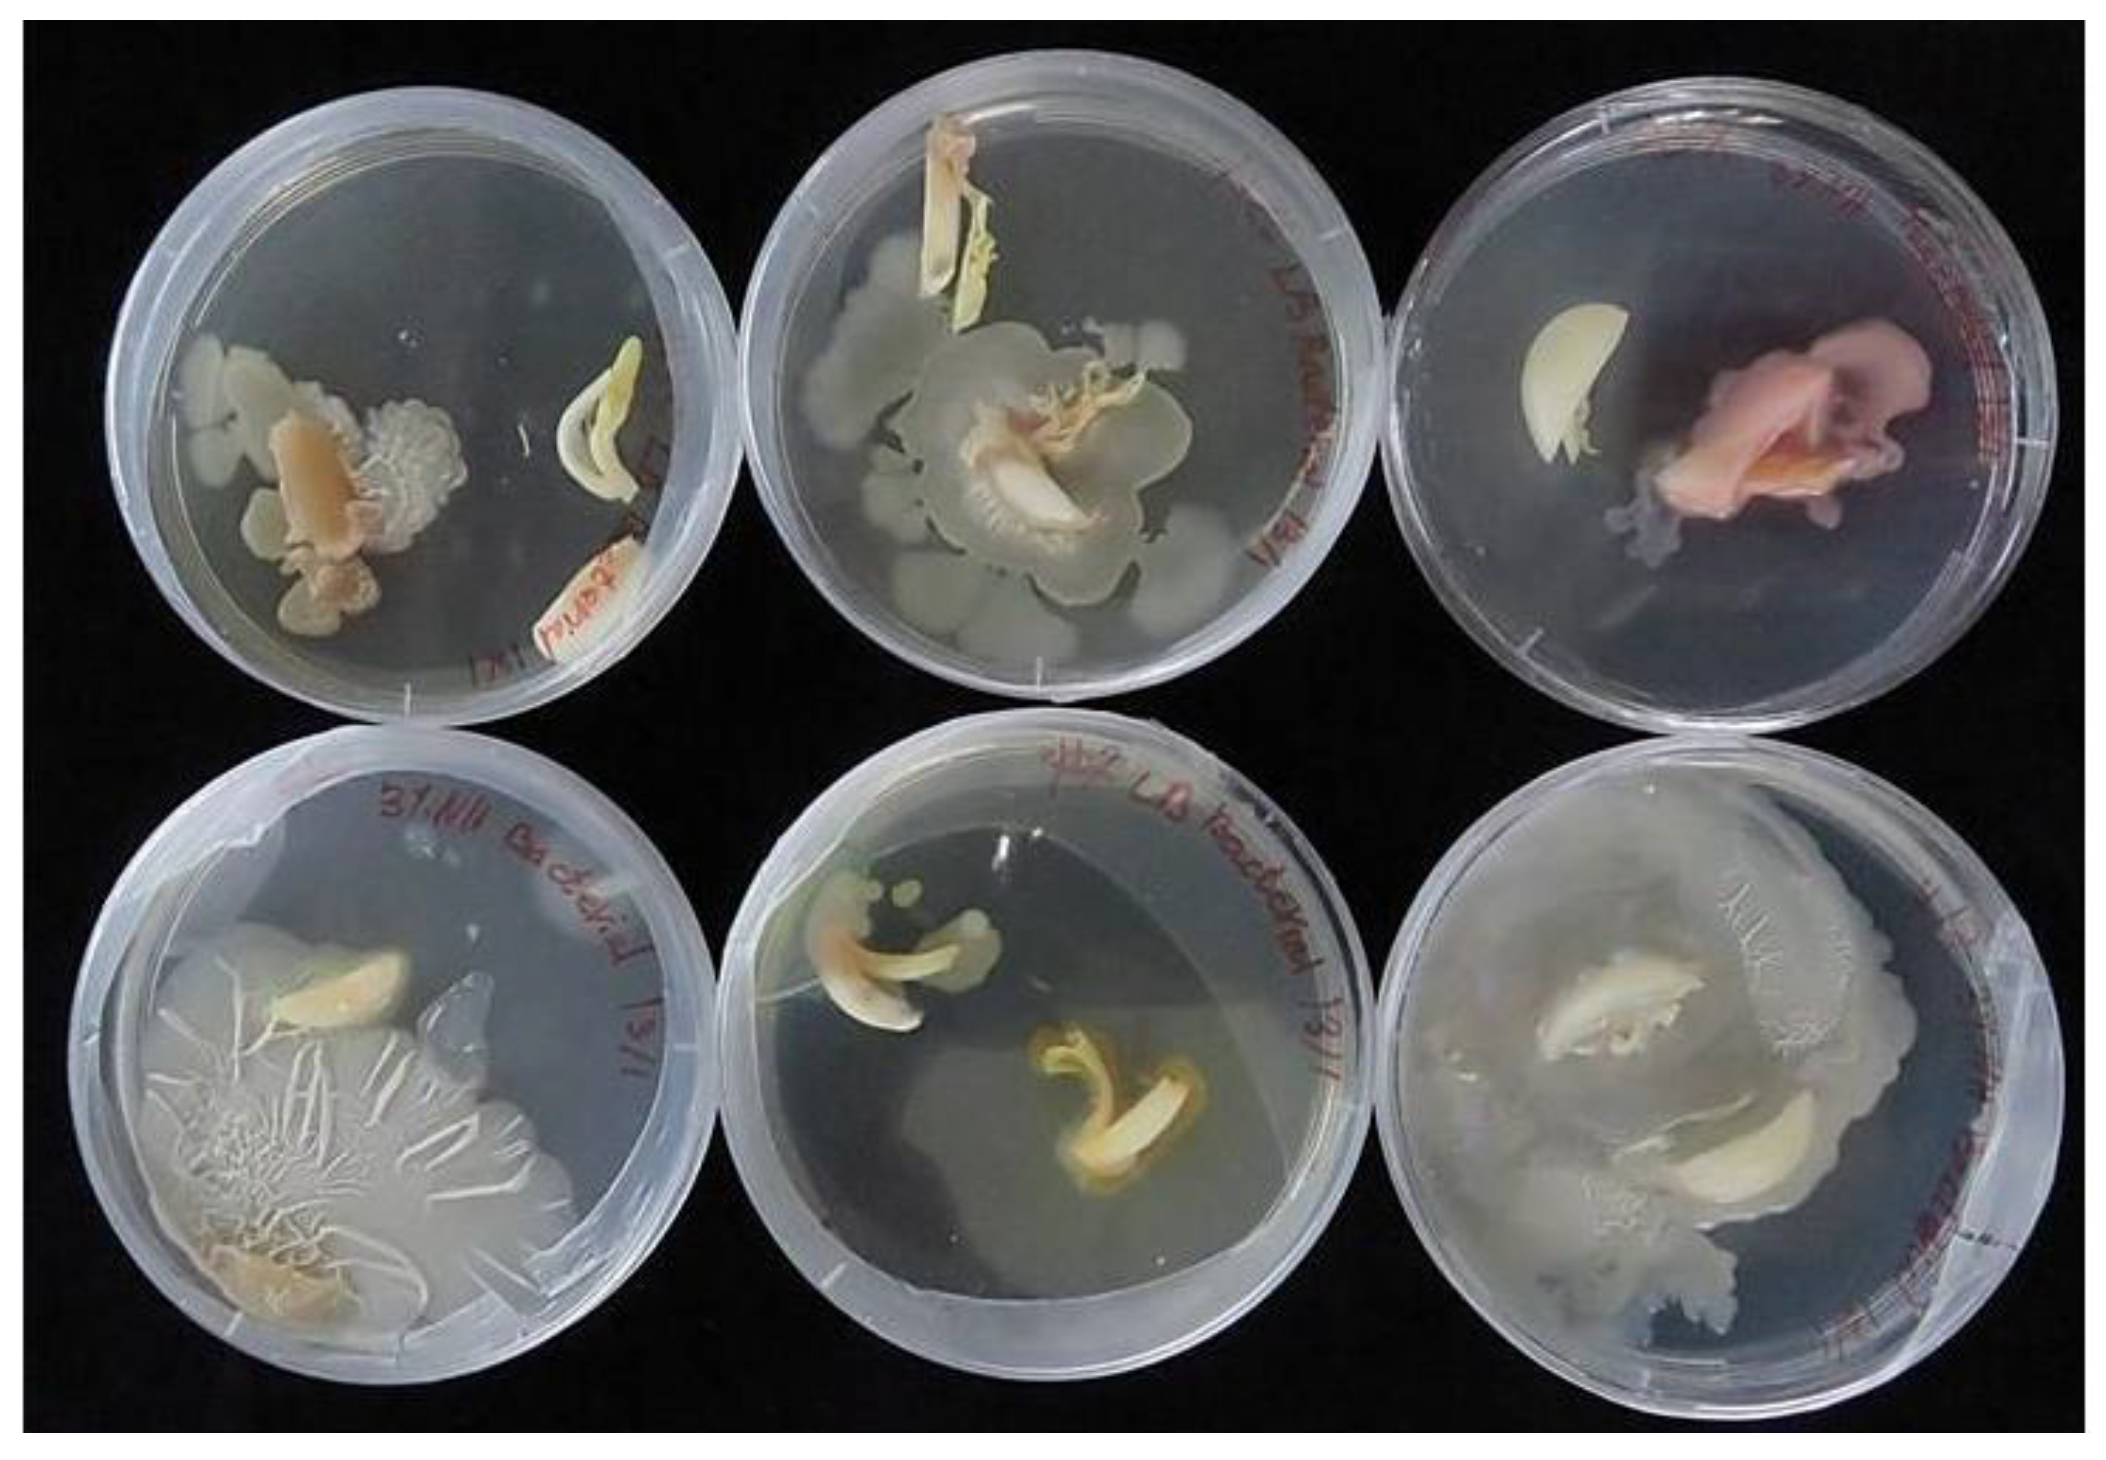
Plants 12 04125 g005 Plants 12 04125 g005

Pathogen Eradication in Garlic in the Phytobiome Context: Should We Aim for Complete Cleaning?
Abstract
1. Introduction
2. Results
2.1. The Mycobiome of Garlic
2.2. The Bacterial Community of Garlic
2.3. Virome of Garlic
2.4. In Vitro Sanitation and Pathogen Eradication
3. Discussion
3.1. Garlic Bulb as a Holobiont
3.2. Complete Elimination of Microflora by In Vitro Sanitation Is Not Essential for Garlic Production
4. Materials and Methods
4.1. Plant Material
4.2. Garlic Microbiome
4.2.1. Transcriptome Analysis
4.2.2. Assessment of Fungal Flora
4.2.3. Assessment of Bacterial Flora
4.2.4. PCR Detection of Poty-, Allexi- and Carlaviruses
4.3. Sanitation Procedures In Vitro
4.3.1. Cryotherapy
4.3.2. Shoot Tip Culture
4.3.3. Post-Culture Procedures No Conclusion Section in This Paper
Supplementary Materials
Author Contributions
Funding
Data Availability Statement
Conflicts of Interest
References
- Vannier, N.; Agler, M.; Hacquard, S. Microbiota-mediated disease resistance in plants. PLoS Pathog. 2019, 15, e1007740. [Google Scholar] [CrossRef]
- Ali, S.; Tyagi, A.; Bae, H. Plant microbiome: An ocean of possibilities for improving disease resistance in plants. Microorganisms 2023, 11, 392. [Google Scholar] [CrossRef] [PubMed]
- Zhao, L.; Wang, M.; Li, J.; Cui, Z.; Volk, G.M.; Wang, Q. Cryobiotechnology: A double-edged sword for obligate plant pathogens. Plant Dis. 2019, 103, 1058–1067. [Google Scholar] [CrossRef]
- Wang, M.R.; Bi, W.L.; Bettoni, J.C.; Zhang, D.; Volk, G.M.; Wang, Q.C. Shoot tip cryotherapy for plant pathogen eradication. Plant Pathol. 2022, 71, 1241–1254. [Google Scholar] [CrossRef]
- Schwartz, H.F.; Mohan, S.K. Compendium of Onion and Garlic Diseases and Pests, 2nd ed.; The American Phytopathological Society: St Paul, MN, USA, 2008. [Google Scholar]
- Wang, J.; Shi, L.; Wang, D.; Li, L.; Loake, G.J.; Yang, X.; Jiang, J. White rot disease protection and growth promotion of garlic (Allium sativum) by endophytic bacteria. Plant Pathol. 2019, 68, 1543–1554. [Google Scholar] [CrossRef]
- Valdez, J.G.; Makuch, M.A.; Ordovini, A.F.; Masuelli, R.W.; Overy, D.P.; Piccolo, R.J. First report of Penicillium allii as a field pathogen of garlic (Allium sativum). Plant Pathol. 2006, 55, 583. [Google Scholar] [CrossRef]
- Moharam, M.H.A.; Farrag, E.S.H.; Mohamed, M.D.A. Pathogenic fungi in garlic seed cloves and first report of Fusarium proliferatum causing cloves rot of stored bulbs in upper Egypt. Arch. Phytopathol. Plant Prot. 2013, 46, 2096–2103. [Google Scholar] [CrossRef]
- Salomon, R. Virus diseases in garlic and the propagation of virus-free plants. In Allium Crop Science: Recent Advances; CABI Publishing: Wallingford, UK, 2002; pp. 311–327. [Google Scholar]
- Manjunathagowda, D.C.; Gopal, J.; Archana, R.; Asiya, K.R. Virus–free seed production of garlic (Allium sativum L.): Status and prospects. Int. J. Curr. Microbiol. App. Sci. 2017, 6, 2446–2456. [Google Scholar]
- Da Silva, L.A.; Oliveira, A.S.; Melo, F.L.; Ardisson-Araújo, D.M.P.; Resende, F.V.; Resende, R.O.; Ribeiro, B.M. A new virus found in garlic virus complex is a member of possible novel genus of the family Betaflexiviridae (order Tymovirales). PeerJ 2019, 7, e6285. [Google Scholar] [CrossRef]
- Bereda, M.; Paduch-Cichal, E. Allexiviruses—Pathogens of garlic plants. Prog. Plant Prot. 2016, 56, 302–311. [Google Scholar]
- Cremer, J.; Campbell, P.; Steele, V.; Persley, D.; Thomas, J.; Harper, S.; Gambley, C. Detection and distribution of viruses infecting garlic crops in Australia. Plants 2021, 10, 1013. [Google Scholar] [CrossRef] [PubMed]
- Shakeel, Q.; Li, G.; Long, Y.; Tahir, H.A.S. Development and implementation of IDM program for annual and perennial Crops. In Plant Disease Management Strategies for Sustainable Agriculture through Traditional and Modern Approaches; Ul Haq, I., Ijaz, S., Eds.; Sustainability in Plant and Crop Protection; Springer: Cham, Switzerland, 2020; Volume 13, pp. 3–15. [Google Scholar]
- Vieira, R.L.; da Silva, A.L.; Zaffari, G.R.; Steinmacher, D.A.; Fraga, H.P.F.; Guerra, M.P. Efficient elimination of virus complex from garlic (Allium sativum L.) by cryotherapy of shoot tips. Acta Physiol. Plant 2015, 37, 1733. [Google Scholar] [CrossRef]
- Kaya, E.; Galatali, S.; Guldag, S.; Celik, O. A new perspective on cryotherapy: Pathogen elimination using plant shoot apical meristem via cryogenic techniques. In Plant Stem Cells: Methods and Protocols; Naseem, M., Dandekar, T., Eds.; Springer Science & Business Media, LLC: Cham, Switzerland, 2020; pp. 269–282. [Google Scholar]
- Taşkin, H.; Baktemur, G.; Kurul, M.; Büyükalaca, S. Use of tissue culture techniques for producing virus-free plant in garlic and their identification through real-time PCR. Sci. World J. 2013, 2013, 781282. [Google Scholar] [CrossRef]
- Keller, E.J.; Zanke, C.D.; Senula, A.; Breuing, A.; Hardeweg, B.; Winkelmann, T. Comparing costs for different conservation strategies of garlic (Allium sativum L.) germplasm in genebanks. Genet. Resour. Crop Evol. 2013, 60, 913–926. [Google Scholar] [CrossRef][Green Version]
- Tanaka, D.; Sakuma, Y.; Yamamoto, S.; Valle Arizaga, M.; Niino, T. Development of −80 °C storage for Allium shoot tips using D cryo-plate method. Plant Cell Tissue Organ Cult. 2021, 144, 115–122. [Google Scholar] [CrossRef]
- Zalcberg, L. Garlic-High Yielding and Virus–Free for Greater Profits; Rural Industries Research and Development Corporation: Wagga Wagga, Australia, 2000.
- Shemesh-Mayer, E.; Kamenetsky Goldstein, R. Recent advances in sexual propagation and breeding of garlic. Hortic. Rev. 2018, 46, 1–38. [Google Scholar]
- Sánchez-Cañizares, C.; Jorrín, B.; Poole, P.S.; Tkacz, A. Understanding the holobiont: The interdependence of plants and their microbiome. Curr. Opin. Microbiol. 2017, 38, 188–196. [Google Scholar] [CrossRef]
- Trivedi, P.; Leach, J.E.; Tringe, S.G.; Sa, T.; Singh, B.K. Plant-microbiome interactions: From community assembly to plant health. Nat. Rev. Microbiol. 2020, 18, 607–621. [Google Scholar] [CrossRef]
- Lucaciu, R.; Pelikan, C.; Gerner, S.M.; Zioutis, C.; Köstlbacher, S.; Marx, H.; Herbold, C.W.; Schmidt, H.; Rattei, T. A bioinformatics guide to plant microbiome analysis. Front. Plant Sci. 2019, 10, 1313. [Google Scholar] [CrossRef]
- Roossinck, M.J.; Martin, D.P.; Roumagnac, P. Plant virus metagenomics: Advances in virus discovery. Phytopathology 2015, 105, 716–727. [Google Scholar] [CrossRef]
- Takahashi, H.; Fukuhara, T.; Kitazawa, H.; Kormelink, R. Virus latency and the impact on plants. Front. Microbiol. 2019, 10, 2764. [Google Scholar] [CrossRef] [PubMed]
- Sharma, S.; Kashyap, P.L.; Sharma, A. Plant virome: Current understanding, mechanisms, and role in phytobiome. In Microbiomes and Plant Health; Academic Press: Cambridge, MA, USA, 2021; pp. 53–81. [Google Scholar]
- Nerva, L.; Garcia, J.F.; Favaretto, F.; Giudice, G.; Moffa, L.; Sandrini, M.; Cantu, D.; Zanzotto, A.; Gardiman, M.; Velasco, R.; et al. The hidden world within plants: Metatranscriptomics unveils the complexity of wood microbiomes. J. Exp. Bot. 2022, 73, 2682–2697. [Google Scholar] [CrossRef] [PubMed]
- Kim, N.K.; Lee, H.J.; Kim, S.M.; Jeong, R.D. Identification of viruses infecting oats in Korea by metatranscriptomics. Plants 2022, 11, 256. [Google Scholar] [CrossRef] [PubMed]
- Shakya, M.; Lo, C.C.; Chain, P.S. Advances and challenges in metatranscriptomic analysis. Front. Genet. 2019, 10, 904. [Google Scholar] [CrossRef] [PubMed]
- Stošić, S.; Ristić, D.; Gašić, K.; Starović, M.; Ljaljević Grbić, M.; Vukojević, J.; Živković, S. Talaromyces minioluteus: New postharvest fungal pathogen in Serbia. Plant Dis. 2020, 104, 656–667. [Google Scholar] [CrossRef] [PubMed]
- Yadav, A.N. Beneficial plant-microbe interactions for agricultural sustainability. J. Appl. Biol. Biotechnol. 2021, 9, i–iv. [Google Scholar] [CrossRef]
- Keusgen, M. Health and Alliums. In Allium Crop Science—Recent Advances; Rabinowitch, H.D., Currah, L., Eds.; CABI Publishing: Wallingford, UK, 2002; pp. 357–378. [Google Scholar]
- Block, E. Garlic and Other Alliums: The Lore and the Science; Royal Society of Chemistry: Cambridge, UK, 2009; 454p. [Google Scholar]
- Borlinghaus, J.; Albrecht, F.; Gruhlke, M.C.; Nwachukwu, I.D.; Slusarenko, A.J. Allicin: Chemistry and biological properties. Molecules 2014, 19, 12591–12618. [Google Scholar] [CrossRef]
- Shim, S.T.; Kyung, K.H. Natural microflora of prepeeled garlic and their resistance to garlic antimicrobial activity. Food Microbiol. 1999, 16, 165–172. [Google Scholar] [CrossRef][Green Version]
- Pozo, M.J.; Zabalgogeazcoa, I.; Vazquez de Aldana, B.R.; Martinez-Medina, A. Untapping the potential of plant mycobiomes for applications in agriculture. Curr. Opin. Plant Biol. 2021, 60, 102034. [Google Scholar] [CrossRef]
- Joshi, M.; Bhargava, P.; Bhatt, M.; Kadri, S.; Shri, M.; Joshi, C.G. Dacrymycetaceae. In Mushrooms of Gujarat; Fungal Diversity Research Series; Springer: Singapore, 2021. [Google Scholar]
- Gálvez, L.; Palmero, D. Fusarium dry rot of garlic bulbs caused by Fusarium proliferatum: A Review. Horticulturae 2022, 8, 628. [Google Scholar] [CrossRef]
- Boekhout, T.; Theelen, B.; Houbraken, J.; Robert, V.; Scorzetti, G.; Gerson, U.; Sztejnberg, A. Novel anamorphic mite-associated fungi belonging to the Ustilaginomycetes: Meira geulakonigii gen. nov., sp. nov., Meira argovae sp. nov. and Acaromyces ingoldii gen. nov., sp. nov. Int. J. Syst. Evolut. Microbiol. 2003, 53, 1655–1664. [Google Scholar] [CrossRef] [PubMed]
- Ment, D.; Raman, S.; Gal, S.; Ezra, D.; Palevsky, E. Interactions of Metarhizium brunneum-7 with phytophagous mites following different application strategies. Insects 2020, 11, 330. [Google Scholar] [CrossRef] [PubMed]
- Gupta, R.; Keppanan, R.; Leibman-Markus, M.; Rav-David, D.; Elad, Y.; Ment, D.; Bar, M. The Entomopathogenic fungi Metarhizium brunneum and Beauveria bassiana promote systemic immunity and confer resistance to a broad range of pests and pathogens in tomato. Phytopathology 2022, 112, 784–793. [Google Scholar] [CrossRef] [PubMed]
- Giraffe, G. Enterococcus. In Encyclopedia of Food Microbiology, 2nd ed.; Batt, C.A., Tortorello, M.L., Eds.; Elsevier Academic Press: Cambridge, MA, USA, 2014; pp. 674–679. [Google Scholar]
- Fang, J.Y. Antibacterial activities of bacteriocins: Application in foods and pharmaceuticals. Front. Microbiol. 2014, 5, 241. [Google Scholar]
- Kasimin, M.E.; Shamsuddin, S.; Molujin, A.M.; Sabullah, M.K.; Gansau, J.A.; Jawan, R. Enterocin: Promising Biopreservative Produced by Enterococcus sp. Microorganisms 2022, 10, 684. [Google Scholar] [CrossRef]
- Lebreton, F.; Willems, R.J.L.; Gilmore, M.S. Enterococcus Diversity, Origins in Nature, and Gut Colonization. In Enterococci: From Commensals to Leading Causes of Drug Resistant Infection; Gilmore, M.S., Clewell, D.B., Ike, Y., Eds.; Massachusetts Eye and Ear Infirmary: Boston, MA, USA, 2014. [Google Scholar]
- Sarbadhikary, S.B.; Mandal, N.C. Field application of two plant growth promoting rhizobacteria with potent antifungal properties. Rhizosphere 2017, 3, 170–175. [Google Scholar] [CrossRef]
- Miljaković, D.; Marinković, J.; Balešević-Tubić, S. The significance of Bacillus spp. in disease suppression and growth promotion of field and vegetable crops. Microorganisms 2020, 8, 1037. [Google Scholar] [CrossRef]
- Gontia, I.; Kavita, K.; Schmid, M.; Hartmann, A.; Jha, B. Brachybacterium saurashtrense sp. nov., a halotolerant root-associated bacterium with plant growth-promoting potential. Int. J. Syst. Evolut. Microbiol. 2011, 61, 2799–2804. [Google Scholar] [CrossRef]
- Alexander, A.; Singh, V.K.; Mishra, A. Interaction of the novel bacterium Brachybacterium saurashtrense JG06 with Arachis hypogaea leads to changes in physio-biochemical activity of plants to cope with nitrogen starvation conditions. Plant Physiol. Biochem. 2021, 166, 974–984. [Google Scholar] [CrossRef]
- Bjelić, D.; Ignjatov, M.; Marinković, J.; Milošević, D.; Nikolić, Z.; Gvozdanović-Varga, J.; Karaman, M. Bacillus isolates as potential biocontrol agents of Fusarium clove rot of garlic. Zemdirb. Agric. 2018, 105, 369–376. [Google Scholar] [CrossRef]
- Balbinot, W.G.; Rodrigues, S.; Botelho, G.R. Isolates of Bacillus sp. from garlic: Effect on corn development and plant growth-promoting mechanisms. Rev. Bras. Ciênc. Solo 2020, 44, e0200043. [Google Scholar] [CrossRef]
- Costa Júnior, P.S.P.; Cardoso, E.J.B.N.; de Oliveira, C.A.; de Souza, R.G. Combined effect of biofertilizers and garlic extract on lettuce growth and soil microbiota. Rhizosphere 2020, 15, 100220. [Google Scholar]
- Li, E.; Tian, X.; Zhao, R.; Wang, Y.; Wang, G. First Report of Enterobacter cloacae causing bulb decay on garlic in China. Plant Dis. 2021. [Google Scholar] [CrossRef] [PubMed]
- Jacques, M.A.; Luçon, N.; Houdault, S. Clove-transmissibility of Pseudomonas salomonii, the causal agent of ‘Café au lait’ disease of garlic. Eur. J. Plant Pathol. 2009, 124, 695–700. [Google Scholar] [CrossRef]
- Sawada, H.; Horita, H.; Nishimura, F.; Mori, M. Pseudomonas salomonii, another causal agent of garlic spring rot in Japan. J. Gen. Plant Pathol. 2020, 86, 180–192. [Google Scholar] [CrossRef]
- Da Silva, W.; Kutnjak, D.; Xu, Y.; Giovannoni, J.; Elena, S.F.; Gray, S. Transmission modes affect the population structure of potato virus Y in potato. PLoS Pathog. 2020, 16, e1008608. [Google Scholar] [CrossRef]
- Shemesh-Mayer, E.; Gelbart, D.L.; Belausov, E.; Sher, N.; Daus, A.; Rabinowitch, H.D.; Kamenetsky-Goldstein, R. Garlic Potyviruses are translocated to the true seeds through the vegetative and reproductive systems of the mother plant. Viruses 2022, 14, 2092. [Google Scholar] [CrossRef] [PubMed]
- Fayad-André, M.D.S.; Dusi, A.N.; Resende, R.O. Spread of viruses in garlic fields cultivated under different agricultural production systems in Brazil. Trop. Plant Pathol. 2011, 36, 341–349. [Google Scholar] [CrossRef]
- Delecolle, B.; Lot, H.; Michel, M.J. Application of ELISA for detecting onion yellow dwarf virus in garlic and shallot seeds and plants. Phytoparasitica 1985, 13, 266–267. [Google Scholar]
- Conci, V.C.; Perotto, M.C.; Cafrune, E.; Lunello, P. A program for the intensive production and protocol optimization for the production of virus-free garlic plants. Acta Hortic. 2005, 688, 195–200. [Google Scholar] [CrossRef]
- Shemesh-Mayer, E.; Kamenetsky-Goldstein, R. Traditional and novel approaches in garlic (Allium sativum L.) breeding. In Advances in Plant Breeding Strategies: Vegetable Crops, Volume 8: Bulbs, Roots and Tubers; Springer International Publishing: Berlin/Heidelberg, Germany, 2021; pp. 3–49. [Google Scholar]
- Juškevičiene, D.; Karkleliene, R.; Radzevicius, A.; Rugienius, R. Survival and state of garlic explants of two Lithuanian cultivars after cryopreservation. Horticulturae 2023, 9, 476. [Google Scholar] [CrossRef]
- Mang, S.M.; Altieri, L.; Candido, V.; Miccolis, V.; Camele, I. Garlic (Allium spp.) viruses: Detection, distribution and remediation attempts in a European garlic collection. Not. Bot. Horti Agrobot. 2022, 50, 12779. [Google Scholar] [CrossRef]
- Chaturvedi, A.K.; Rohkin Shalom, S.; Faigenboim-Doron, A.; Teper-Bamnolker, P.; Salam, B.B.; Daus, A.; Kamenetsky, R.; Eshel, D. Differential carbohydrate gene expression during preplanting temperature treatments controls meristem termination and bulbing in garlic. Environ. Exp. Bot. 2018, 150, 280–291. [Google Scholar] [CrossRef]
- Chang, S.; Puryear, J.; Cairney, J. A simple and efficient method for isolating RNA from pine trees. Plant Mol. Biol. Rep. 1993, 11, 113–116. [Google Scholar] [CrossRef]
- Grabherr, M.G.; Haas, B.J.; Yassour, M.; Levin, J.Z.; Thompson, D.A.; Amit, I.; Adiconis, X.; Fan, L.; Raychowdhury, R.; Zeng, Q.; et al. Full-length transcriptome assembly from RNA-Seq data without a reference genome. Nat. Biotechnol. 2011, 29, 644–652. [Google Scholar] [CrossRef] [PubMed]
- Buchfink, B.; Xie, C.; Huson, D.H. Fast and sensitive protein alignment using DIAMOND. Nat. Methods 2015, 12, 59–60. [Google Scholar] [CrossRef] [PubMed]
- Conesa, A.; Götz, S.; García-Gómez, J.M.; Terol, J.; Talón, M.; Robles, M. Blast2GO: A universal tool for annotation, visualization and analysis in functional genomics research. Bioinformatics 2005, 21, 3674–3676. [Google Scholar] [CrossRef] [PubMed]
- Li, H. Aligning sequence reads, clone sequences and assembly contigs with BWA-MEM. arXiv 2013, arXiv:1303.3997. [Google Scholar]
- Li, R.; Li, Y.; Kristiansen, K.; Wang, J. SOAP: Short oligonucleotide alignment program. Bioinformatics 2008, 24, 713–714. [Google Scholar] [CrossRef]
- Schwartz, H.F.; du Toit, L.J.; Coutinho, T. Diseases of Onion and Garlic (Allium cepa L. and A. sativum L., Respectively); The American Phytopathological Society: St Paul, MN, USA, 2015. [Google Scholar]
- Lacey, L.A. Manual of Techniques in Invertebrate Pathology, 2nd ed.; Academic Press: Cambridge, MA, USA, 2012. [Google Scholar]
- Etminani, F.; Harighi, B. Isolation and identification of endophytic bacteria with plant growth promoting activity and biocontrol potential from wild pistachio trees. Plant Pathol. J. 2018, 34, 208–217. [Google Scholar] [CrossRef] [PubMed]
- Murashige, T.; Skoog, F. A revised medium for rapid growth and bioassays with tobacco tissue cultures. Physiol. Plant 1962, 15, 473–497. [Google Scholar] [CrossRef]
- Sambrook, J.; Russell, D.W. Molecular Cloning: A Laboratory Manual; Cold Spring Harbor Laboratory: Cold Spring Harbor, NY, USA, 2001. [Google Scholar]
- Olas-Sochacka, M. Preservation of garlic (Allium sativum L.) genetic resources in cryobank. Zesz. Nauk. Inst. Ogrod. 2017, 25, 85–93. [Google Scholar]

| Fungal Genus | Warehouse, Ambient Conditions | Storage at Dark, 4 °C for 8 Months | ||
|---|---|---|---|---|
| Internal | External | Internal | External | |
| Penicillium | 13% | 60% | 19% | 84% |
| Aspergillus | 0% | 53% | 6% | 34% |
| Fusarium | 0% | 20% | 3% | 38% |
| Mucor | 0% | 0% | 0% | 3% |
| No fungi | 87% | 13% | 72% | 3% |
| Target Virus | Primer | Sequence (5′–3′) | Expected Fragment Size, bp |
|---|---|---|---|
| RS1 Conserved Potyvirus sequence | 9725R | 5′- TGC TGT GTG CCT CTC CGT GTC CTC -3′ | |
| LYSV | Forward 9147 | 5′- GAG GAA AGT CAA TAC TTA AC-3′ | 578 |
| OYDV | Forward 9565 | 5′- GAG GAT GCA CAA TCA AG - 3’ | 714 |
| Degenerative Allexiviruses | Forward 7457 | 5′- GCW TGG RCB TGC TAY CAC AAY GG -3′ | 725 |
| Reverse 8182 | 5′- CYT TCA GCA TRT AGC TTA GCR GGT CC - -3′ | ||
| Carlaviruses | Forward 5296 | 5′- CTG AAT CAG ATT ATG AAG CTT TTG ATG C- 3’ | 949 |
| Reverse 6246 | 5’ - CAA TCA CCC AGC TGG TAT TCG TC - 3’ |
Disclaimer/Publisher’s Note: The statements, opinions and data contained in all publications are solely those of the individual author(s) and contributor(s) and not of MDPI and/or the editor(s). MDPI and/or the editor(s) disclaim responsibility for any injury to people or property resulting from any ideas, methods, instructions or products referred to in the content. |
© 2023 by the authors. Licensee MDPI, Basel, Switzerland. This article is an open access article distributed under the terms and conditions of the Creative Commons Attribution (CC BY) license (https://creativecommons.org/licenses/by/4.0/).
Share and Cite
Yarmus, I.; Gelbart, D.; Shemesh-Mayer, E.; Teper, D.D.; Ment, D.; Faigenboim, A.; Peters, R.; Kamenetsky-Goldstein, R. Pathogen Eradication in Garlic in the Phytobiome Context: Should We Aim for Complete Cleaning? Plants 2023, 12, 4125. https://doi.org/10.3390/plants12244125
Yarmus I, Gelbart D, Shemesh-Mayer E, Teper DD, Ment D, Faigenboim A, Peters R, Kamenetsky-Goldstein R. Pathogen Eradication in Garlic in the Phytobiome Context: Should We Aim for Complete Cleaning? Plants. 2023; 12(24):4125. https://doi.org/10.3390/plants12244125
Chicago/Turabian StyleYarmus, Itay, Dana Gelbart, Einat Shemesh-Mayer, Doron Dov Teper, Dana Ment, Adi Faigenboim, Ross Peters, and Rina Kamenetsky-Goldstein. 2023. "Pathogen Eradication in Garlic in the Phytobiome Context: Should We Aim for Complete Cleaning?" Plants 12, no. 24: 4125. https://doi.org/10.3390/plants12244125
APA StyleYarmus, I., Gelbart, D., Shemesh-Mayer, E., Teper, D. D., Ment, D., Faigenboim, A., Peters, R., & Kamenetsky-Goldstein, R. (2023). Pathogen Eradication in Garlic in the Phytobiome Context: Should We Aim for Complete Cleaning? Plants, 12(24), 4125. https://doi.org/10.3390/plants12244125

